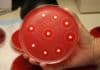
Researchers find Novel Evolutionary Pathways of Drug Resistance by Spreading E.coli on MEGA Petri Dish

ICBHE – 2018 | International Conference On Bioengineering On Health And Environment By...
International Conference On
Bioengineering On Health And Environment
ICBHE - 2018
8th -10th January, 2018
Live Streaming of ICBHE - 2018
Watch It Live From 8th Jan -...
Biotecnika Times – Newsletter 13.11.2017
Govt Job @ WII - Wildlife Institute of India | Project Fellow Post for MSc
The Wildlife Institute of India, Dehra Dun invites application for...
BioTecNika Chennai Inauguration Pics, Videos & Event Updates
Dear Folks,
It was really overwhelming meeting you all at our Biotecnika Chennai Office. Here are the pics, Videos & Event updates as they happened...
Crested Pigeons Use Whistling Feathers for Danger Tip-off
Crested Pigeons Use Whistling Feathers for Danger Tip-off
Most city dwellers would agree that pigeons are sentient garbage. They eat pizza off the ground and...
Combined Ultrasound and Electric Field Stimulation Device Cleared By the FDA to Treat Chronic...
Ultrasound and Electric Field Stimulation to Treat Chronic Wounds
A Jerusalem-based medical device company developing and marketing innovative products for increasing blood flow and...
Healing By Misdirection: Nanoparticles Distract Immune Cells to Reduce Inflammation
Nano-particles Distract Immune Cells to Reduce Inflammation
Most of us, no matter how many time-saving techniques we employ, don’t have enough time to waste. But...
ASCO Warns of Cancer Risks Associated with Alcohol Consumption
ASCO Warns of Cancer Risks Associated with Alcohol Consumption
Moderate amounts - even as little as a glass of wine or beer a day -of alcohol consumption...
Merck Receives FDA Approval of its CMV drug Prevymis
Merck Receives FDA Approval of its CMV drug Prevymis
The USFDA has now announced the approval of Merck’s Prevymis (letermovir) tablets and injection, the first...
Takeda’s dengue vaccine produces promising results in trial, reduces Incidence of Dengue in Children...
Takeda’s dengue vaccine produces promising results in a trial
Takeda’s dengue candidate TAK-003 has now shown a high protective efficacy rate in the DEN-204 trial,...
Torrent Pharma All Set to Acquire Unichem Labs’ India Business
Torrent Pharma All Set to Acquire Unichem Labs' India Business
Ahmadabad-based Flagship Company of the Torrent Group, Torrent Pharmaceuticals, has now announced that it will...
FDA Approves World’s First Non-Magnetic MRI Monitor
FDA Approves World's First Non-Magnetic MRI Monitor
Thinly traded micro cap iRadimed has now announced 510(k) clearance from the FDA for its 3880 MR-compatible patient...
Biotecnika Times – Newsletter 10.11.2017
Research Scholars Program - II - 2017 @ CDFD (Centre for DNA Fingerprinting and Diagnostics)
The CDFD (Centre for DNA Fingerprinting and Diagnostics), Hyderabad, is...
Bausch + Lomb and Nicox Announce FDA Approval of Vyzulta for open-angle glaucoma and...
Bausch + Lomb and Nicox Announce FDA Approval of Vyzulta
Vizsla, the first prostaglandin analog with one of its metabolites being nitric oxide (NO), has...
NIH Handing Out 10,000 Fitbits to Gather Vital Health Data for its All of...
NIH Handing Out 10,000 Fitbits to Gather Vital Health Data
Fitbit has been tussling with Apple and Xiaomi when it comes to market share in the wearables field and...
“Sugar-Glass” Wraps Use Viruses to Kill Bacteria and Preserve Your Food
“Sugar-Glass” Wraps Use Viruses to Kill Bacteria and Preserve Your Food
Using viruses to kill bacteria. Alas, the irony!
With antibiotic resistance on the rise, bacterial...